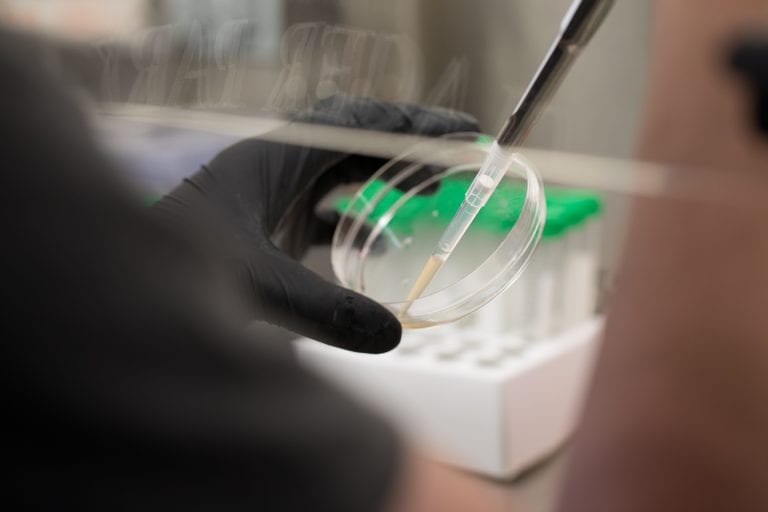

If we want to defeat osteosarcoma, a formidable bone cancer, we must put a powerful force behind research. That’s why CCRF’s Zach Sobiech Osteosarcoma Fund is proud to unite with five funding partners to back The Fight Osteosarcoma Together (FOT) Super Grant, a new three-year, $1.5 million dollar grant to fight recurring osteosarcoma.
Today’s osteosarcoma protocol, a combination of surgery and chemotherapy, has been used since the 1970s. The protocol significantly raised survival rates to 70% for kids whose cancer hasn’t spread, but those who relapse still face dismal rates of 20-30%. Four decades have gone by, and no new drugs have been approved to treat kids facing osteosarcoma. We desperately need new targeted treatments for the kids who don’t respond to known treatments, who need a new path outside of current osteosarcoma protocols to survive.
“This collaboration allows us to attract quality researchers with promising ideas, paving the path to a new understanding of osteosarcoma,” said Laura Sobiech, co-founder of the Zach Sobiech Osteosarcoma Fund and mom to Zach, who passed away from osteosarcoma in 2013. “We always do better when we work together, and we need to do better for kids fighting osteosarcoma.”
The collaboration awarded the first grant to Patrick Grohar, MD, PhD at Children’s Hospital of Philadelphia. The grant is nearly as large as a National Institutes of Health R01 grant, but with a shorter time span. “The idea is to try to get something done for these patients quickly,” said Dr. Grohar. He will spend the next three years researching a family of genes called MYC, with the larger goal of discovering targeted treatments for kids with MYC-amplified osteosarcoma.
MYC genes go awry in 12-39% of osteosarcoma patients and could be linked to osteosarcoma’s aggressive and deadly behavior. “One of the aims of our grant is to see what about MYC makes [osteosarcoma] high-risk,” said Dr. Grohar. He knows no single researcher can do this alone.
“We put together a really great team,” said Dr. Grohar, who has brought together experts from all corners of cancer research to study osteosarcoma MYC-amplification. The team includes chemical biologist Nouri Neamati, PhD, a MYC expert, pharmaceutical company Vuja De Sciences, a Memorial Sloan Kettering sarcoma expert, Filemon Dela Cruz, MD and Chand Khanna, DVM, PHD, DACVIM (ONC), DACVP (HON), a veterinarian who has studied both pediatric and canine osteosarcoma for 20 years. Already, colleague Dr. Neamati believes he has a compound that could be the perfect match for MYC-amplified osteosarcoma.
You can read more about their research here.
“We didn’t have the resources to go at it in the way that we needed to: To see something valuable in the clinic in a time frame that’s reasonable. That’s what’s great about this grant. It allows us to go all in, leverage our own resources, take the experience of others who have worked in MYC [and metastases], and bring them into the fold to think about this particular pediatric cancer,” said Dr. Grohar.
Funding partners: Battle Osteosarcoma, CureSearch for Children's Cancer, Michael & April Egge, Osteosarcoma Collaborative, St. Baldrick's Foundation and The Zach Sobiech Osteosarcoma Fund.
Your donation funds researchers like Grohar.
Your support propels bold ideas forward and empowers researchers to discover treatments that are better and safer for kids, and ensure every child can have a long, healthy life after cancer.